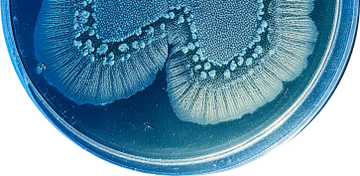

Your trusted partner in accelerating scientific breakthroughs
We offer a comprehensive, reliable range of biotech products and services, tailored to meet the unique
requirements of your projects.

Driving success in research since 1998
At Innovative Research, we are committed to delivering unparalleled quality. Our rigorously tested products support the integrity of your research. With ISO-certified processes and competitive pricing, we deliver premium materials without compromising your budget.
We stand firmly by our products and are dedicated to providing exceptional customer support. Additionally, we prioritize efficient delivery, guaranteeing that you receive your products right when you need them.
Our products
By Type
By Research Area
Certifications and registrations
-
ISO 9001:2015
Certified Company
-
FDA Registered
Certified Company
-
USDA Approved
Animal Collection Facilities
Here to aid your next big discovery
-
CRO Services
Get seamless research solutions precisely tailored to your needs. As a Contract Research Organization (CRO), our experts provide the most comprehensive support, from sample testing to in-depth analysis.
-
Custom Orders
We bring precision and flexibility right to your reach. Whether you need small-scale samples or large-scale batches, we customize your orders to your exact specifications.
-
Timed Deliveries
When your project stays on track, you stay ahead. Our precise delivery schedules promise that your research materials arrive exactly when you need them.
-
I used Innovative Research’s pooled human cerebrospinal fluid (CSF) for my assays at the Goldberg Lab in City of Hope studying CAR T cell functionality in CSF.
I was very pleased with the quality of the product, as well as the care and attention we received from sales and customer service.”Assistant Professor, City of Hope National Medical Center
Dr. Lior Goldberg
-
We measured total fibrinogen level in the mouse plasma samples with the Mouse Total Fibrinogen ELISA kit. The kit is convenient and user-friendly."
Assistant Professor, Wayne State UniversityInstitute of Environmental Health SciencesDepartment of Pharmacology
Dr. Michael Petriello
-
Extremely pleased with the results from a custom project from Innovative Research, Inc. I received a high-quality custom lab product, with on-time delivery and great communication from the sales office staff. Great company!”
Technical Support Scientist, Cell Sciences
Anne Sloan, PhD
The latest in science and research
-
Product References
Breakthrough ELISA & CLIA Kits from Innovative Research
By Adam Awdish On Aug 16, 2024At Innovative Research, we're committed to providing cutting-edge tools that empower your scientific discoveries. Our premium selection of human immunoassay...
-
Product References
In Stock Alert: Human and Animal-sourced tPA
By Wendy Wise On Jun 05, 2024Understanding Human Tissue Plasminogen Activator (tPA) tPA is an essential enzyme in the body that helps break down blood clots...
-
Product References
Trending ELISA Kits, Designed with You in Mind - Order Now While Supplies Last
By Adam Awdish On May 22, 2024We currently have overstock of some of our current most popular ELISA Kits, including coagulation factor kits, IgG, tPA, and...